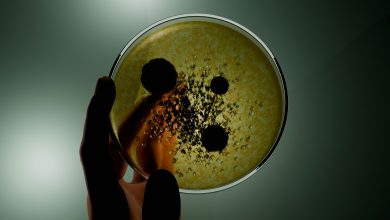
Photo of E. coli and mould found on item millions of Brits use daily

You have probably heard a lot before about the importance of green spaces in urban areas, but have you ever wondered why?
You will have to agree that greenery makes any urban space nicer to look at, but that is not the only reason why cities choose to add plants around. In fact, today, we will give you five reasons why urban green spaces are more important than ever.
1-Climate change
One of the main reasons green spaces are so important in urban areas is that they help with climate change and global warming. An article published in Science Direct, titled Urban Green Spaces Enhance Climate Change Mitigation in Cities of the Global South: The Case of Kumasi, Ghana, says that UGS or urban green spaces contribute to mitigating climate change impacts. This is possible via carbon sequestration; in other words, they filter CO2.
Besides, green spaces help save water and electricity consumption, filter general environmental pollution and capture heavy metals from the environment.
2-For health
Another great reason to have green spaces in urban areas is health. Yes, they are proven to benefit people’s health by cleaning the air from pollutants and therefore counteracting respiratory diseases.
An article on New Scientist suggests that a reason why people seem to need to be around nature so much is that “on evolutionary timescales, urban living is a new invention. Our species has existed for at least 300,000 years, but the oldest cities are only some 6000 years old”, they say.
They also explain that studies have found concrete links between health and increased exposure to nature. However, the benefits are not only on physical health but also on mental health.
Take a look at this infographic that Venngage published last year regarding the impact of the coronavirus on the environment. By diminishing the amount of human activities, the environment reacted positively.
It is also believed that working near green spaces helps with your concentration and overall performance. They can also can reduce stress and anxiety! So, whenever you are feeling anxious, pressured, or sad, visit a local park or garden and surround yourself with plants. You will feel much better.
You can also add plants to your home and office and create your own green space.
3-Social responsibility
In the UK and other countries in the world, efforts to reduce pollution levels, restoration of parks, and the installation of vertical gardens can be seen taking place more often.
Many people see the benefits of urban green spaces and comprehend their importance to our planet. All of this shows the commitment to recover green areas and help reduce the damage we do to nature.
By committing yourself to this lifestyle, you are also socially responsible.
4-For the environment
This reason seems a little bit obvious, but it is a huge reason to have green spaces in urban areas on our planet. The article from New Scientist mentioned above says that the number of people living in cities is booming. By 2050, they say that projections indicate that almost 70% of the population will be urban dwellers.
The growth of large cities has produced changes in nature and the environment, favoring the construction of large buildings. Unfortunately, in the majority of cases, not enough attention has been paid to green areas.
This is the reason why green spaces contribute to changing things in favor of nature and the environment. By creating parks, rehabilitating greeneries around cities, and more, we can have more green in our lives.
But, what can you do? You can reach out to your local government to donate or plant flowers, trees, and shrubs in your nearby parks or create a vertical garden yourself at home, or even converting your roof into a green space!
5-Promote environmental awareness
Finally, promote awareness of the environment and the need for more green spaces. How can you do that? You can inspire others to take action. Start by being more active by planting, recovering space, and posting on social media what you are doing.
The change is within us, and to create a relevant movement, you need inspiration and support. It may take years for something relevant to occur, but it will never happen if no one takes the first step.
If you want to live a life surrounded by more green spaces, how about creating a mind map with all of the ideas you can implement at home and in your office. Perhaps, you could start a roof or vertical garden or have indoor plants in the office! Whatever you decide to do, we hope you now understand the benefits of urban green spaces in today’s world.
Photos: